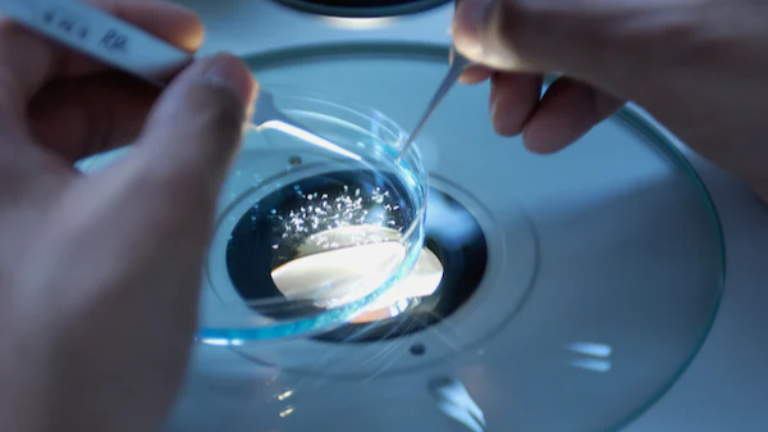
Eyenovia Announces Positive Results from VISION-2 Phase 3 Study of MicroLine as a Potential On-Demand Treatment for Presbyopia

预约演示
更新于:2026-01-30

Microline Surgical, Inc.
更新于:2026-01-30
概览
关联
1
项与 Microline Surgical, Inc. 相关的临床试验NCT05363813
Post-market Clinical Follow-up Study of REusable Clip Applier and Cartridge Devices for LAParoscopic Surgery
This is a Post-Market Clinical Follow-up (PMCF) investigation to determine the long-term effectiveness and safety of the Multi-Fire Clip System in laparoscopic surgery. This system consists of two medical devices, the M/L-10 Clip Applier and the M/L-10 Clip. The Multi-Fire Clip System is indicated for occluding and ligating vessels, ducts, tracts and other tubular structures during laparoscopic and general surgical procedures. This medical device has been marketed in Europe since 2006 and in the United States since 2002, among other places.
Laparoscopic surgeries have become the standard of excellence for many surgical procedures as they allow the intervention to be performed in a minimally invasive way, which means significant improvements in factors such as postoperative pain or length of hospital stay compared to open surgeries. Laparoscopic procedures require the use of different hemostatic techniques to minimize blood loss or leakage of other fluids through their respective ducts. Currently, clip and staple placement are the most commonly used procedures for ligation and/or occlusion of blood vessels and other tubular structures.
In this context, the Multi-Fire Clip System is presented as an alternative device that can produce significant cost savings due to the reusable design of the M/L-10 Clip Applier. It also provides precise control of bleeding during surgery, which could lead to less potential injury to surrounding structures.
The present clinical trial is a PMCF study to evaluate the long-term safety and efficacy of the Multi-Fire Clip System in patients scheduled to undergo laparoscopic surgery in which clip placement is anticipated. During the surgery procedure, the necessary clips will be placed using the aforementioned multi-shot clip system. Participants will be followed up for 6 months after the operation. Through an on-site visit and a telephone call visit, data on possible adverse events related to the device or procedure will be collected in order to assess the long-term safety and efficacy of these devices.
Laparoscopic surgeries have become the standard of excellence for many surgical procedures as they allow the intervention to be performed in a minimally invasive way, which means significant improvements in factors such as postoperative pain or length of hospital stay compared to open surgeries. Laparoscopic procedures require the use of different hemostatic techniques to minimize blood loss or leakage of other fluids through their respective ducts. Currently, clip and staple placement are the most commonly used procedures for ligation and/or occlusion of blood vessels and other tubular structures.
In this context, the Multi-Fire Clip System is presented as an alternative device that can produce significant cost savings due to the reusable design of the M/L-10 Clip Applier. It also provides precise control of bleeding during surgery, which could lead to less potential injury to surrounding structures.
The present clinical trial is a PMCF study to evaluate the long-term safety and efficacy of the Multi-Fire Clip System in patients scheduled to undergo laparoscopic surgery in which clip placement is anticipated. During the surgery procedure, the necessary clips will be placed using the aforementioned multi-shot clip system. Participants will be followed up for 6 months after the operation. Through an on-site visit and a telephone call visit, data on possible adverse events related to the device or procedure will be collected in order to assess the long-term safety and efficacy of these devices.
开始日期2022-10-17 |
申办/合作机构 |
100 项与 Microline Surgical, Inc. 相关的临床结果
登录后查看更多信息
0 项与 Microline Surgical, Inc. 相关的专利(医药)
登录后查看更多信息
4
项与 Microline Surgical, Inc. 相关的新闻(医药)2022-10-21
NEW YORK, Oct. 20, 2022 (GLOBE NEWSWIRE) -- Eyenovia, Inc. (NASDAQ: EYEN), a pre-commercial ophthalmic technology company developing the Optejet® delivery system for use both in combination with its own drug-device therapeutic programs for mydriasis, presbyopia and pediatric progressive myopia as well as out-licensing for additional indications, today announced positive results from its VISION-2 Phase 3 study of MicroLine as a potential topical, on-demand treatment for presbyopia.
The VISION-2 study evaluated the safety and efficacy of Eyenovia’s 2% pilocarpine micro-array print (MAP) formulation versus placebo, all administered via the company’s proprietary Optejet device. VISION-2 is the fourth Phase 3 study demonstrating the utility of the company’s MAP technology in improving the therapeutic index of topical ophthalmic drugs.
Key highlights from the study include:
In a modified per-protocol analysis of evaluable patients, excluding a non-study related adverse event impacting pupil size and reactivity (new onset anisocoria), VISION-2 met its primary endpoint with a statistically significant proportion of subjects treated with MicroLine showing a 15-letter or more improvement in distance corrected near visual acuity (DCNVA) with less than a 5-letter loss in distance acuity versus placebo in low light conditions at two hours post-treatment.
The study also achieved all secondary endpoints at a statistically significant level.
MicroLine was very well tolerated. Adverse events were reported in fewer than 3% of patients, and all were mild and/or transient.
“We are very pleased with these Phase 3 study results which again demonstrate the benefits of our proprietary Optejet device that underpins MicroLine as a potential on-demand treatment for presbyopia,” stated Michael Rowe, Chief Executive Officer of Eyenovia. “We look forward to meeting with the FDA within our planned commercialization timeline in preparation for a potential new drug application (NDA) submission. MicroLine, if approved, would be the only option that is designed to provide the ease-of-use, convenience, and reduced exposure to drug and preservatives that we believe are significant benefits of the Optejet device.”
“Proprietary market research that we conducted in May of this year reveals that 80% of patients in our target market surveyed would prefer the Optejet device over traditional eyedrops. That market consists of presbyopes between the ages of 40 and 55 years who have otherwise never needed to wear glasses. We view Optejet as a significant advantage not only for MicroLine, but for our entire pipeline of development programs, including MydCombi for pharmacologic mydriasis, for which we are preparing to resubmit our New Drug Application (NDA), and MicroPine for progressive myopia,” Mr. Rowe concluded.
“The positive results from this study confirm earlier findings that MicroLine may represent an exciting new on-demand treatment option for the millions of people who suffer from presbyopia who never had to wear reading glasses previously,” stated April Jasper, OD, medical monitor and scientific advisor to the company. “Of note in this study is the very low incidence of side effects, such as headache and brow ache, that are often associated with topical pilocarpine treatments. This is due to the precision dispensing of the Optejet, which coats the corneal surface without exposing the eye to excess drug and preservative toxicity. I look forward to incorporating this novel technology into my own practice if and when approved.”
The VISION-2 study was a double-masked, placebo-controlled, cross-over superiority trial in which 140 subjects with presbyopia were treated. During the study, subjects were randomly assigned to a treatment sequence for dosing with pilocarpine 2% as well as placebo, both administered via the Optejet dispenser. The primary endpoint was improvement in high contrast binocular distance corrected near visual acuity without loss of distance vision measured in low light conditions 2 hours after treatment.
About the VISION Trials
The VISION trials are Phase 3, double-masked, placebo-controlled, cross-over superiority trials that enroll participants with presbyopia. The primary endpoint is improvement in high-contrast binocular distance corrected near visual acuity without loss of distance vision in low light conditions. MicroLine is intended for the “on demand” improvement of near vision in people with presbyopia.
About MicroLine for Presbyopia
MicroLine (pilocarpine ophthalmic solution) is Eyenovia’s investigational pharmacologic treatment for presbyopia. Presbyopia or farsightedness is the non-preventable, age-related hardening of the lens, which causes a gradual loss of the eye’s ability to focus on nearby objects and is estimated to affect nearly 113 million Americans. Treatment options are typically device-based, such as reading glasses and contact lenses. Pilocarpine ophthalmic solution is known to constrict the pupil and improve near-distance vision by creating an extended depth of focus through its small aperture effect. Eyenovia believes that its administration of pilocarpine using the Company’s high precision microdosing technology could provide a meaningful improvement in near vision while enhancing tolerability and usability. MicroLine has been licensed to Arctic Vision (Hong Kong) Limited in Greater China and South Korea.
About MicroPine for Progressive Myopia
MicroPine (atropine ophthalmic spray) is Eyenovia’s investigational, potentially first-in-class topical treatment for the reduction of pediatric myopia progression, also known as nearsightedness, in children ages 3-12. It has been developed for comfort and ease-of-use in children, and its microdose administration is designed to potentially result in low systemic and ocular drug exposure. MicroPine has been licensed to Bausch+Lomb, Inc. in the United States and Canada, and Arctic Vision (Hong Kong) Limited in Greater China and South Korea.
About Mydcombi™ for Mydriasis
Mydcombi is Eyenovia's investigational, first-in-class fixed-dose-combination product (tropicamide 1% and phenylephrine 2.5% ophthalmic spray) for pharmacologic mydriasis (eye dilation), which is targeted to improve the efficiency of the estimated 100 million office-based comprehensive eye exams performed every year in the United States, as well as the estimated 4 million pharmacologic mydriasis applications for cataract surgery. Developed as a micro-formulation for use without anesthetic, Eyenovia believes Mydcombi will help improve the efficacy, tolerability, and efficiency of pharmacologic mydriasis. Mydcombi has been licensed to Arctic Vision (Hong Kong) Limited in Greater China and South Korea.
合作First in Class临床结果
2022-06-28
SAN FRANCISCO, June 28, 2022 /PRNewswire/ -- A new market study published by Global Industry Analysts Inc., (GIA) the premier market research company, today released its report titled "Minimally Invasive Surgical Instruments - Global Market Trajectory & Analytics". The report presents fresh perspectives on opportunities and challenges in a significantly transformed post COVID-19 marketplace.
FACTS AT A GLANCE
Global Industry Analysts Predicts the World Minimally Invasive Surgical Instruments Market to Reach $27.5 Billion by 2026
What's New for 2022?
Global competitiveness and key competitor percentage market shares
Market presence across multiple geographies - Strong/Active/Niche/Trivial
Online interactive peer-to-peer collaborative bespoke updates
Access to our digital archives and MarketGlass Research Platform
Complimentary updates for one year
Edition: 9;
Released: January 2022
Executive Pool: 16829
Companies: 44 - Players covered include Abbott Laboratories; B. Braun Melsungen AG; ConMed Corporation; Ethicon US LLC; Medtronic PLC; Microline Surgical, Inc.; Smith & Nephew PLC; Stryker Corporation; Zimmer Biomet Holdings, Inc. and Others.
Coverage: All major geographies and key segments
Segments: Product (Handheld Instruments, Inflation Devices, Cutter Instruments, Guiding Devices, Electrosurgical Devices, Auxiliary Devices, Monitoring & Visualization Devices)
Geographies: World; United States; Canada; Japan; China; Europe (France; Germany; Italy; United Kingdom; and Rest of Europe); Asia-Pacific; Rest of World.
Complimentary Project Preview - This is an ongoing global program. Preview our research program before you make a purchase decision. We are offering a complimentary access to qualified executives driving strategy, business development, sales & marketing, and product management roles at featured companies. Previews provide deep insider access to business trends; competitive brands; domain expert profiles; and market data templates and much more. You may also build your own bespoke report using our MarketGlass™ Platform which offers thousands of data bytes without an obligation to purchase our report.
Preview Registry
ABSTRACT-
Global Minimally Invasive Surgical Instruments Market to Reach $27.5 Billion by 2026
Amid the COVID-19 crisis, the global market for Minimally Invasive Surgical Instruments estimated at US$17.5 Billion, is projected to reach a revised size of US$27.5 Billion by 2026, growing at a CAGR of 7.6% over the analysis period. Handheld Instruments, one of the segments analyzed in the report, is projected to record a 6.3% CAGR and reach US$7.3 Billion by the end of the analysis period. After a thorough analysis of the business implications of the pandemic and its induced economic crisis, growth in the Inflation Devices segment is readjusted to a revised 9.1% CAGR for the next 7-year period.
The U.S. Market is Estimated at $5.7 Billion in 2021, While China is Forecast to Reach $4.8 Billion by 2026
The Minimally Invasive Surgical Instruments market in the U.S. is estimated at US$5.7 Billion in the year 2021. China, the world`s second largest economy, is forecast to reach a projected market size of US$4.8 Billion by the year 2026 trailing a CAGR of 7.2% over the analysis period. Among the other noteworthy geographic markets are Japan and Canada, each forecast to grow at 6.9% and 6.3% respectively over the analysis period. Within Europe, Germany is forecast to grow at approximately 6.4% CAGR.
Cutter Instruments Segment to Reach US$2.7 Billion by the year 2026
In the global Cutter Instruments segment, USA, Canada, Japan, China and Europe will drive the 6.5% CAGR estimated for this segment. These regional markets accounting for a combined market size of US$1.5 Billion will reach a projected size of US$2.3 Billion by the close of the analysis period. China will remain among the fastest growing in this cluster of regional markets.
More
MarketGlass™ Platform
Our MarketGlass™ Platform is a free full-stack knowledge center that is custom configurable to today`s busy business executive`s intelligence needs! This influencer driven interactive research platform is at the core of our primary research engagements and draws from unique perspectives of participating executives worldwide. Features include - enterprise-wide peer-to-peer collaborations; research program previews relevant to your company; 3.4 million domain expert profiles; competitive company profiles; interactive research modules; bespoke report generation; monitor market trends; competitive brands; create & publish blogs & podcasts using our primary and secondary content; track domain events worldwide; and much more. Client companies will have complete insider access to the project data stacks. Currently in use by 67,000+ domain experts worldwide.
Our platform is free for qualified executives and is accessible from our website or via our just released mobile application on iOS or Android
About Global Industry Analysts, Inc. & StrategyR™
Global Industry Analysts, Inc., () is a renowned market research publisher the world`s only influencer driven market research company. Proudly serving more than 42,000 clients from 36 countries, GIA is recognized for accurate forecasting of markets and industries for over 33 years.
CONTACTS:
Zak Ali
Director, Corporate Communications
Global Industry Analysts, Inc.
Phone: 1-408-528-9966
Email: [email protected]
LINKS
Join Our Expert Panel
Connect With Us on LinkedIn
Follow Us on Twitter
Journalists & Media
[email protected]
SOURCE Global Industry Analysts, Inc.
合作
2021-11-11
DURHAM, N.C., Nov. 11, 2021 (GLOBE NEWSWIRE) -- Aerami Therapeutics, Inc., a leader in the field of developing inhaled therapies to treat severe respiratory and chronic diseases, today announced the appointment of Darlene Deptula–Hicks, Chief Financial Officer of F-star Therapeutics, Inc., to its board of directors and chair of the audit committee.
“I am delighted to welcome Darlene to our board of directors,” said Steve Thornton, chief executive officer of Aerami. “She is a seasoned financial executive who brings decades of experience in business development and corporate finance having worked with both private and public life science companies. We look forward to her strategic operational and financial guidance as we advance AER-901, our drug-device combination product candidate inhaled imatinib for the treatment of pulmonary arterial hypertension which is currently in a Phase 1 trial.”
Ms. Deptula-Hicks’ biopharmaceutical industry experience spans more than 30 years and includes serving in finance executive leadership positions and on the board of directors. She’s served as the Chief Financial Officer of F-star Therapeutics, Inc. (NASDAQ:FSTX) since May 2019 and operated Crimson Consulting LLC, a strategic and financial consulting services company, since January 2018. Prior to that, she served as acting Chief Financial Officer for Northern Biologics, Inc. Ms. Deptula-Hicks has previously served in a number of senior executive positions including as Senior Vice President and Chief Financial Officer of T2 Biosystems, Inc., Senior Vice President and Chief Financial Officer of Pieris Pharmaceuticals, Inc. and as Vice President and Chief Financial Officer of Microline Surgical, Inc. She currently serves on the board of directors of Abcuro, Inc. and previously served on the board of directors of Giner Life Sciences, and on the board of directors and as audit committee chair of Xentic Biosciences, US Falcon, Inc., Technest Holdings, Inc. and IMCOR Pharmaceuticals. Ms. Deptula-Hicks received an M.B.A. from Rivier University and a B.S. in Accounting from Southern New Hampshire University.
Ms. Deptula-Hicks added, “I am honored to join the Aerami Therapeutics board of directors at this exciting time of growth and look forward to working with the board and management team as we advance inhaled therapies to significantly improve the quality of life for people with severe respiratory and chronic diseases.”
About Aerami Therapeutics
Aerami Therapeutics is a clinical stage biopharmaceutical company developing inhaled therapies to treat severe respiratory and chronic diseases. The Company’s lead development program is AER-901, a drug-device combination product candidate, inhaled imatinib for the treatment of pulmonary arterial hypertension currently in Phase1. It has been developed as a nebulized formulation to improve drug uptake and dosing consistency. AER-901 is designed to deliver consistent, therapeutically effective, and well tolerated levels of imatinib through once-a-day inhalation via the Fox® device, licensed from Vectura Group plc, which is both 510k cleared and CE marked. More information can be found at
This press release contains “forward-looking statements” concerning the development and commercialization of Aerami’s product candidates, out-licensing arrangements, timing of clinical trials, the company’s business development efforts and its expectations regarding its prospects. Forward-looking statements are subject to risks, assumptions and uncertainties that could cause actual future events or results to differ materially from such statements, including risks associated with the clinical development process and the ability to obtain funding to support planned clinical activities. These statements are made as of the date of this press release. Actual results may vary. Aerami undertakes no obligation to update any forward-looking statements for any reason.
Investor Contact
Jeremy Feffer
LifeSci Advisors
Tel: (212) 915-2568
jeremy@lifesciadvisors.com
Media Contact
Gloria Gasaatura
LifeSci Communications
Tel: (646) 970-4688
ggasaatura@lifescicomms.com
100 项与 Microline Surgical, Inc. 相关的药物交易
登录后查看更多信息
100 项与 Microline Surgical, Inc. 相关的转化医学
登录后查看更多信息
组织架构
使用我们的机构树数据加速您的研究。
登录
或

管线布局
2026年02月08日管线快照
无数据报导
登录后保持更新
药物交易
使用我们的药物交易数据加速您的研究。
登录
或

转化医学
使用我们的转化医学数据加速您的研究。
登录
或

营收
使用 Synapse 探索超过 36 万个组织的财务状况。
登录
或

科研基金(NIH)
访问超过 200 万项资助和基金信息,以提升您的研究之旅。
登录
或

投资
深入了解从初创企业到成熟企业的最新公司投资动态。
登录
或

融资
发掘融资趋势以验证和推进您的投资机会。
登录
或

生物医药百科问答
全新生物医药AI Agent 覆盖科研全链路,让突破性发现快人一步
立即开始免费试用!
智慧芽新药情报库是智慧芽专为生命科学人士构建的基于AI的创新药情报平台,助您全方位提升您的研发与决策效率。
立即开始数据试用!
智慧芽新药库数据也通过智慧芽数据服务平台,以API或者数据包形式对外开放,助您更加充分利用智慧芽新药情报信息。
生物序列数据库
生物药研发创新
免费使用
化学结构数据库
小分子化药研发创新
免费使用